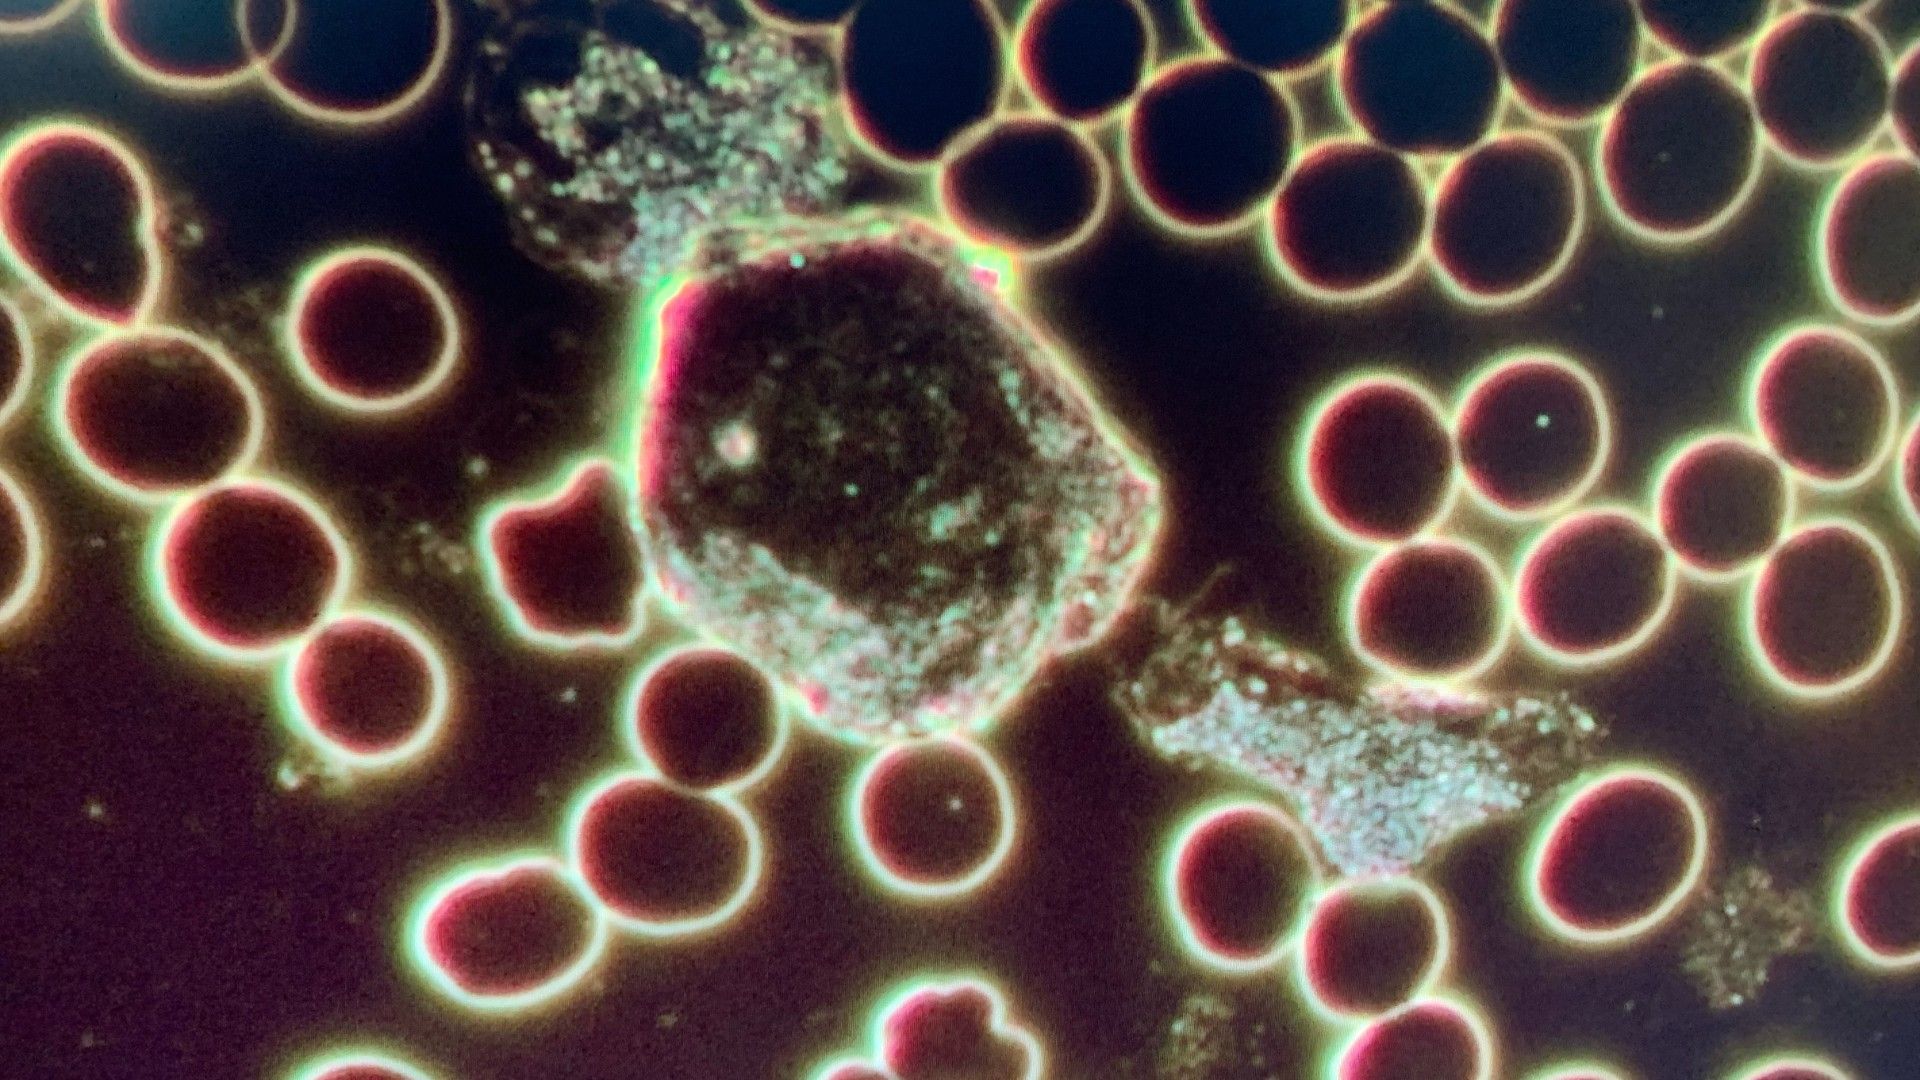
Live Blood Analysis Mississauga

LIVE & DRY BLOOD CELL ANALYSIS
Services > Lab Tests & Products > Live & Dry Blood Cell Analysis
LIVE & DRY BLOOD CELL ANALYSIS
Live & Dry Blood Cell Analysis Is...
Live Blood Analysis is the use of a high-resolution dark field microscope to observe your red blood cells, immune system (white blood cells) and the plasma (river that carries the blood through our body).
A small drop of blood is taken from the finger with a small poke using a lancet. We put the blood on a slide and place the slide under the microscope.
The blood is then viewed "live" on a monitor, and we go through the slide and point out everything seen and you get an up-close view of your blood.
Blood is the most precious and complex tissue that our body produces. Blood is a biological fluid of great importance; it feeds every cell in the body, clears away wastes and toxins and is a communication highway for hormonal, chemical and enzymatic signals. Although it is a fluid, blood is a body tissue that connects all our body’s organs and systems. It contains more than just red blood cells and white blood cells; it contains plasma which flows like a tidal river out of the blood into the extracellular fluid, where it bathes and nourishes every cell in our body, collecting cellular products and cellular waste before flowing back into the blood again.

Every moment of our lives our body’s cells, tissues and organs are continually driven to work in harmony with each other to maintain our health. If our body does not have all the resources, it needs at any given moment, it will adapt and divert its resources to cope with demands. When the body is not replenished, its ability to adapt and regenerate diminishes.
It is important to look inside our body every now and then to get a sense of how well it is functioning, we could find out whether it is deficient in any nutrients or resources, assess the health and vitality of various systems and organs, and adapt our lifestyle to help our body maintain optimum health.
What Can Be Seen In The Blood:
- Stress
- Immune function
- Inflammation
- Liver Toxins
- Oxidative Stress
- Vitamin and Mineral Deficiency
- Acidity and pH Imbalance
- Bacteria
- Dehydration
- Parasites
- Undigested Fats and Proteins

Blood transports oxygen and nutrients throughout the entire body to maintain health. Looking at the blood is a great way of seeing live what is happening inside our bodies and an incentive to make dietary and lifestyle changes.
All life is dependent upon the health of each cell. The health of each cell is dependent upon the internal terrain of the body.
As a Live and Dry Blood Analyst, we do not diagnose, instead we look at the red and white blood cells, we look at how the blood is moving, the health of the cells, what kind of debris may be causing a circulation hindrance. We are building the story of what we see in your blood and any imbalances can be worked on. We cannot fix things unless we know what needs to be fixed!
Book a FREE 15 minute consultation or appointment with our Live Blood Analyst. Contact us or call 905-891-3865.
Book An Appointment or Free 15 mins ConsultationFREQUENTLY ASKED QUESTIONS
Do I get any data or a report after my live blood analysis?
Can you please explain the procedure?
Book a FREE 15 minute consultation or appointment with our Live Blood Analyst. Contact us or call 905-891-3865.
Book An Appointment or Free 15 mins ConsultationSubscribe to our newsletter to get healthy lifestyle tips and stay informed about upcoming events and clinic news.

